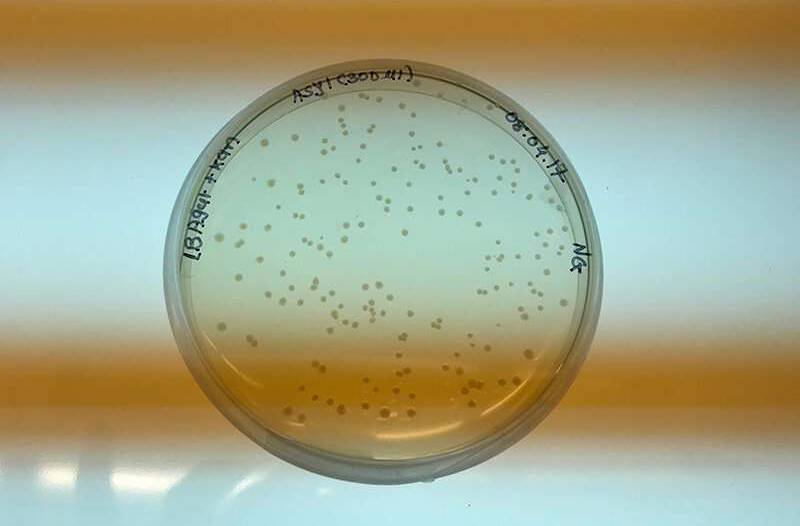

Tạo ra loại lúa mì và đậu phộng ít gây dị ứng hơn
Sachin Rustgi, một thành viên thuộc Hiệp hội Khoa học Cây trồng Hoa Kỳ, đã nghiên cứu cách chúng ta sử dụng phương pháp nhân giống để phát triển các loại thực phẩm ít gây dị ứng hơn. Mới đây, Rustgi đã trình bày nghiên cứu của mình tại Hội nghị thường niên trực tuyến ASA-CSSA-SSSA 2020.
Vi khuẩn nuôi trong đĩa petri này có thể vận chuyển vật liệu gene từ một cây sang cây khác. Đây chính là công nghệ DNA tái tổ hợp. Nguồn: Jonathan Windham
Bộ Nông nghiệp Hoa Kỳ xác định một nhóm 8 thực phẩm gây ra 90% trường hợp dị ứng thực phẩm, trong đó có thực phẩm từ lúa mì và đậu phộng. Dĩ nhiên là có thể ngăn ngừa dị ứng do lúa mì và đậu phộng bằng cách tránh xa những loại thực phẩm này “nhưng trên thực tế lại rất khó”, Rustgi nói.
Tránh xa lúa mì và đậu phộng đồng nghĩa với việc đánh mất các lựa chọn thực phẩm lành mạnh. Hai loại thực phẩm này là ‘kho báu’ dinh dưỡng. Lúa mì là nguồn cung cấp năng lượng, chất xơ và vitamin tuyệt vời. Đậu phộng thì cung cấp protein, chất béo tốt, vitamin và khoáng chất.
Rustgi và cộng sự đang sử dụng quá trình nhân giống cây trồng và kỹ thuật di truyền để phát triển các giống lúa mì và đậu phộng ít gây dị ứng hơn. Mục tiêu của họ là giúp những người bị ứng có thêm lựa chọn thực phẩm. Đối với lúa mì, các nhà nghiên cứu tập trung vào một nhóm protein, được gọi là gluten. Gluten trong bột bánh mì giúp bột nhào có tính đàn hồi. Gluten cũng góp phần tạo nên độ dai của bánh mì. Nhưng gluten có thể gây ra phản ứng miễn dịch đối với những người mắc bệnh Celiac (bệnh không dung nạp gluten). Ngoài ra, đối với những người bị nhạy cảm với gluten (không liên quan đến bệnh Celiac), nhóm protein này cũng gây ra nhiều triệu chứng bất lợi cho cơ thể.
Họ đã nỗ lực tạo ra các giống lúa mì có hàm lượng gluten thấp hơn. Cái khó nằm ở bản chất phức tạp của di truyền gluten. Thông tin cần thiết để tạo ra gluten được gắn vào DNA trong tế bào lúa mì. Nhưng gluten không phải là một loại protein đơn lẻ – nó là một nhóm bao gồm nhiều loại protein khác nhau. Các chỉ dẫn cần thiết để tạo ra những protein gluten đơn lẻ được chứa trong các gene khác nhau. Trong lúa mì, các gene gluten này được phân bố trên khắp DNA của tế bào. Vì rất nhiều phần trong DNA đóng vai trò tạo ra gluten nên rất khó để các nhà chọn tạo giống cây trồng có thể lai tạo các giống lúa mì có hàm lượng gluten thấp hơn. “Khó khăn lớn khi chúng tôi bắt đầu tiến hành nghiên cứu này, đó là làm thế nào để giải quyết một đặc tính do nhiều gene kiểm soát như vậy”, Rustgi cho hay.
Đối với đậu phộng, câu chuyện cũng tương tự. Đậu phộng chứa 16 loại protein khác nhau được xác định là chất gây dị ứng. “Không phải tất cả các protein trong đậu phộng đều gây dị ứng như nhau. Bốn loại protein trong số đó gây ra phản ứng dị ứng ở hơn một nửa số người nhạy cảm với đậu phộng”, Rustgi nói.
Nhóm nghiên cứu đang thử nghiệm nhiều loại lúa mì, đậu phộng để tìm ra những loại tự nhiên ít gây dị ứng hơn những loại khác và có thể trồng đại trà. Ngoài các nỗ lực nhân giống truyền thống, Rustgi cũng đang sử dụng kỹ thuật di truyền để giảm các protein gây dị ứng trong lúa mì và đậu phộng, chẳng hạn như áp dụng công nghệ CRISPR để thực hiện những thay đổi chính xác lên DNA của tế bào. Đáng chú ý, những cải tiến gần đây trong công nghệ CRISPR cho phép các nhà nghiên cứu nhắm mục tiêu nhiều gene cùng một lúc.
Nhóm nghiên cứu sử dụng CRISPR nhằm thay đổi hoặc gây đột biến các gene. Điều này có nghĩa là các tế bào không còn có thể ‘đọc’ các gene này để tạo ra các protein cụ thể. “Việc phá hủy các gene gluten trong lúa mì có thể tạo ra loại lúa mì với hàm lượng gluten thấp hơn nhiều. Cách tiếp cận tương tự cũng sẽ hiệu quả đối với đậu phộng”, Rustgi nhận định.
Các cách tiếp cận khác bao gồm tìm hiểu cách điều chỉnh quá trình sản xuất gluten trong tế bào lúa mì. Hóa ra, có một loại protein đóng vai trò như “bộ điều chỉnh chính” cho nhiều gene gluten. Điều đó rất quan trọng vì việc phá hủy bộ điều chỉnh chính này có thể dẫn đến giảm lượng gluten trong lúa mì. Nhắm mục tiêu vào một gene đơn lẻ dễ hơn nhiều so với việc cố gắng phá vỡ nhiều gene gluten. □
Hà Trang dịch
Nguồn: https://phys.org/news/2021-01-wheat-peanuts-allergenic.html
